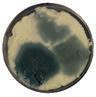

Art
Printing
Sales






■
■ Χωρίς γλουτένη, GMO-free και με πιστοποίηση Kosher & Halal.

www.billtec.gr
Αγαμέμνωνος 61 & Ηρακλείτου 26 | Γλυφάδα
Τηλ: 210 9607 291, 210 5582 433 | info@billtec.gr













EOS Capital Partners
EOS Food Investments.
















TETRA PAK



![]()



























































Art
Printing
Sales






■
■ Χωρίς γλουτένη, GMO-free και με πιστοποίηση Kosher & Halal.

www.billtec.gr
Αγαμέμνωνος 61 & Ηρακλείτου 26 | Γλυφάδα
Τηλ: 210 9607 291, 210 5582 433 | info@billtec.gr













EOS Capital Partners
EOS Food Investments.






















Η Tecma Aries

(conveyors)



Coffee Championships 2026 by SCA Greece




























Andrew Taylor, Executive Vice President of Food & Beverage Biosolutions της Novonesis.











Όταν η γνώση γίνεται πράξη.

waldner.de

Συσκευασία








Europack I.S.



Η Kapelis Packaging
Reepack,
Cassel Messtechnik GmbH, η Boss Vakuum









After-Sales Support
διαδικασιών
και συμμόρφωση με διεθνή πρότυπα διαχείρισης.
Κατηγορίες Μηχανήματων
• Flowpack
• Κάθετα Μηχανήματα
• Tray Sealer
• Doypack
• Δοσομετρικά
• Γραμμές Εμφιάλωσης
• Vacuum
• Θερμοκολλητικά Σακούλας
• Θερμοσυρρικνωτικά (POF & PE)
• Clip & Twist
•
• Thermoforming

• X-Ray, Metal Detectors


Fanuc Robotics, Robopac, Interroll, SSI Schaefer, Intralox,
Email:






GENOMILKS.
• Συμμετοχή στο 13th Ιnternational Conference on Instrumental Methods of Analysis.
• Συμμετοχή στο 10th Ιnternational Conference of Mikrobiokosmos.
• Συμμετοχή στο IAFP European Symposium on Food Safety.
• Συμμετοχή στο 10th International on Sustainable Solid Waste Management.


































































































































































































































































































































































European Regional Focal Point for Animal Genetic Resources (ERFP) με
‘Guidelines for the Constitution of National Cryopreservation Programmes for Farm Animals’







εξής κατηγορίες: •Εμπορικές Εταιρείες •Οργανωμένο Λιανεμπόριο & Χονδρική
•Ηλεκτρονικά Καταστήματα (e-shops)
• Βιομηχανίες & Βιοτεχνίες (υπεύθυνοι procurementwarehouse managers - supply chain managers)
•Mεταφορές - Αποθήκευση - Διανομή - Courier
•Εκτελωνισμοί & Τελωνειακές Απλουστεύσεις
•Οδικές μεταφορές & Διανομές
•Συνδυασμένες Mεταφορές
•Κατασκευές
•Δημόσιοι Οργανισμοί

LOGI.C Conferences:





INRAE Institut Agro,
Rennes



39
Labeling)


















final_tsakanikas-kalogiannis.pdf









11



φέτα, μυζήθρα, βούτυρο κ.ά. προϊόντα τα οποία διοχετεύαμε και στην αγορά της Αθήνας και συγκεκριμένα στα καταστήματα του Κάκια, του Μπανταγιάννη17 ενώ δίναμε και στον Πειραιά στον Τσιρογιάννη18. Μάλιστα κάναμε και

Anthoulakis_KTX.pdf
















ΠΡΟΒΑΤΟΤΡΟΦΙΑ
Aneta Moscicka/








ISBN: 978-618-08-0822-3



